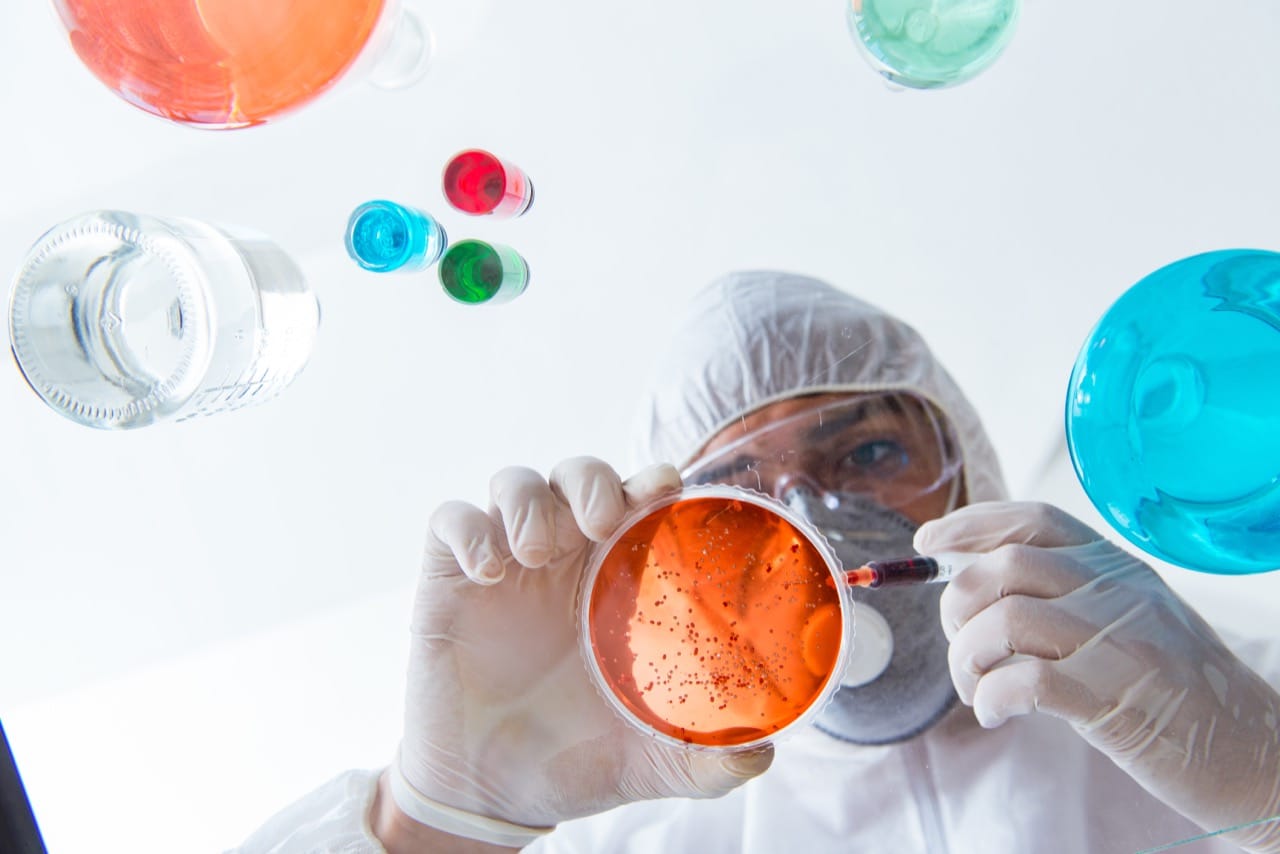
Question 9

Fizz, Bonds, and Brainwaves: The Curious Chemistry Challenge

Atoms are buzzing, beakers are bubbling, and your brain is about to join the reaction. This trivia quiz turns everyday chemistry facts into a playful test of what you really know about the microscopic world. From the air you breathe to the salt on your fries, chemistry quietly rules the scene, and this challenge shines a spotlight on those hidden rules. Expect questions that jump from the periodic table to common lab gear, from states of matter to the particles that make up everything around you. No lab coat required, just curiosity and a bit of scientific spirit. Whether you are brushing up for class, testing your general science knowledge, or simply love fun facts, these questions will keep you guessing, learning, and maybe even laughing at how weirdly wonderful chemistry can be. Ready to see how reactive your brain really is?
1
Which element is essential in all organic compounds by definition?

2
Which subatomic particle has a negative electric charge?

3
Which term describes a substance that speeds up a chemical reaction without being consumed?

4
Which state of matter has a definite volume but no definite shape?

5
Which gas is produced when hydrochloric acid reacts with zinc metal?

6
Which element is represented by the chemical symbol Na?

7
What is the most abundant gas in Earth’s atmosphere by volume?

8
Which pH value represents a neutral solution at room temperature?

9
Which scientist is best known for creating the first widely recognized periodic table of elements?
10
What do we call the smallest unit of a compound that still retains its chemical properties?

11
What is the term for a homogeneous mixture of two or more substances?

12
What is the chemical formula for table salt used in food?

0
out of 12
Quiz Complete!
Fizz, Bonds, and Brainwaves: Exploring the Curious Chemistry Around You

Chemistry might sound like something that lives only in textbooks and laboratories, but it is actually one of the most down‑to‑earth sciences you encounter every day. The air you breathe, the water you drink, the soap you wash with, and even the bubbles in your favorite fizzy drink are all examples of chemistry in action. When you take a quiz on curious chemistry, you are really testing how well you understand the hidden rules that guide the world around you.
At the heart of chemistry are atoms, the tiny building blocks of matter. Everything you can touch, taste, or smell is made of atoms joined together in different combinations. The periodic table is like a map of these atoms, known as elements. Hydrogen, oxygen, carbon, and sodium are just a few of the many elements that show up in everyday life. Water is made of hydrogen and oxygen. The salt on your fries is a combination of sodium and chlorine. Change how atoms are arranged and you change the substance itself.
Atoms do not just sit still; they form bonds with one another. These bonds are like invisible connections that hold atoms together in molecules and compounds. Some bonds share electrons, while others transfer them, creating attractions between positively and negatively charged particles. These simple ideas explain why some substances dissolve in water, why metals conduct electricity, and why certain reactions release light or heat.
States of matter are another key part of chemistry that you see every day. Solids, liquids, and gases behave differently because their particles are arranged and move in different ways. Ice cubes keep their shape, liquid water flows and takes the shape of its container, and water vapor spreads out to fill any space. When you boil water, you are watching a change of state driven by energy. The same particles are present, but their motion and arrangement change.
Reactions are where chemistry gets really fun. When substances react, bonds break and new ones form, creating new materials. Effervescent tablets fizz because they release a gas during a chemical reaction. Rust forming on a bike, bread rising in the oven, and fireworks lighting up the sky are all examples of reactions you might recognize. Some reactions happen slowly, others in a flash, but all of them follow consistent chemical principles.
Even basic lab equipment reflects these ideas. Beakers, test tubes, and flasks are designed to hold, mix, and heat substances safely so we can observe reactions more clearly. While you might not use lab gear at home, you do something similar when you boil pasta, mix ingredients, or chill drinks with ice.
A playful chemistry quiz turns these serious concepts into a game. By answering questions about elements, particles, states of matter, and everyday reactions, you connect classroom ideas to real life. You may find yourself laughing at how strange and surprising some facts are, but behind every odd detail is a simple rule of how matter behaves. In the end, chemistry is less about memorizing formulas and more about seeing patterns in the world. Once you spot them, you realize your brain is more reactive than you thought.







